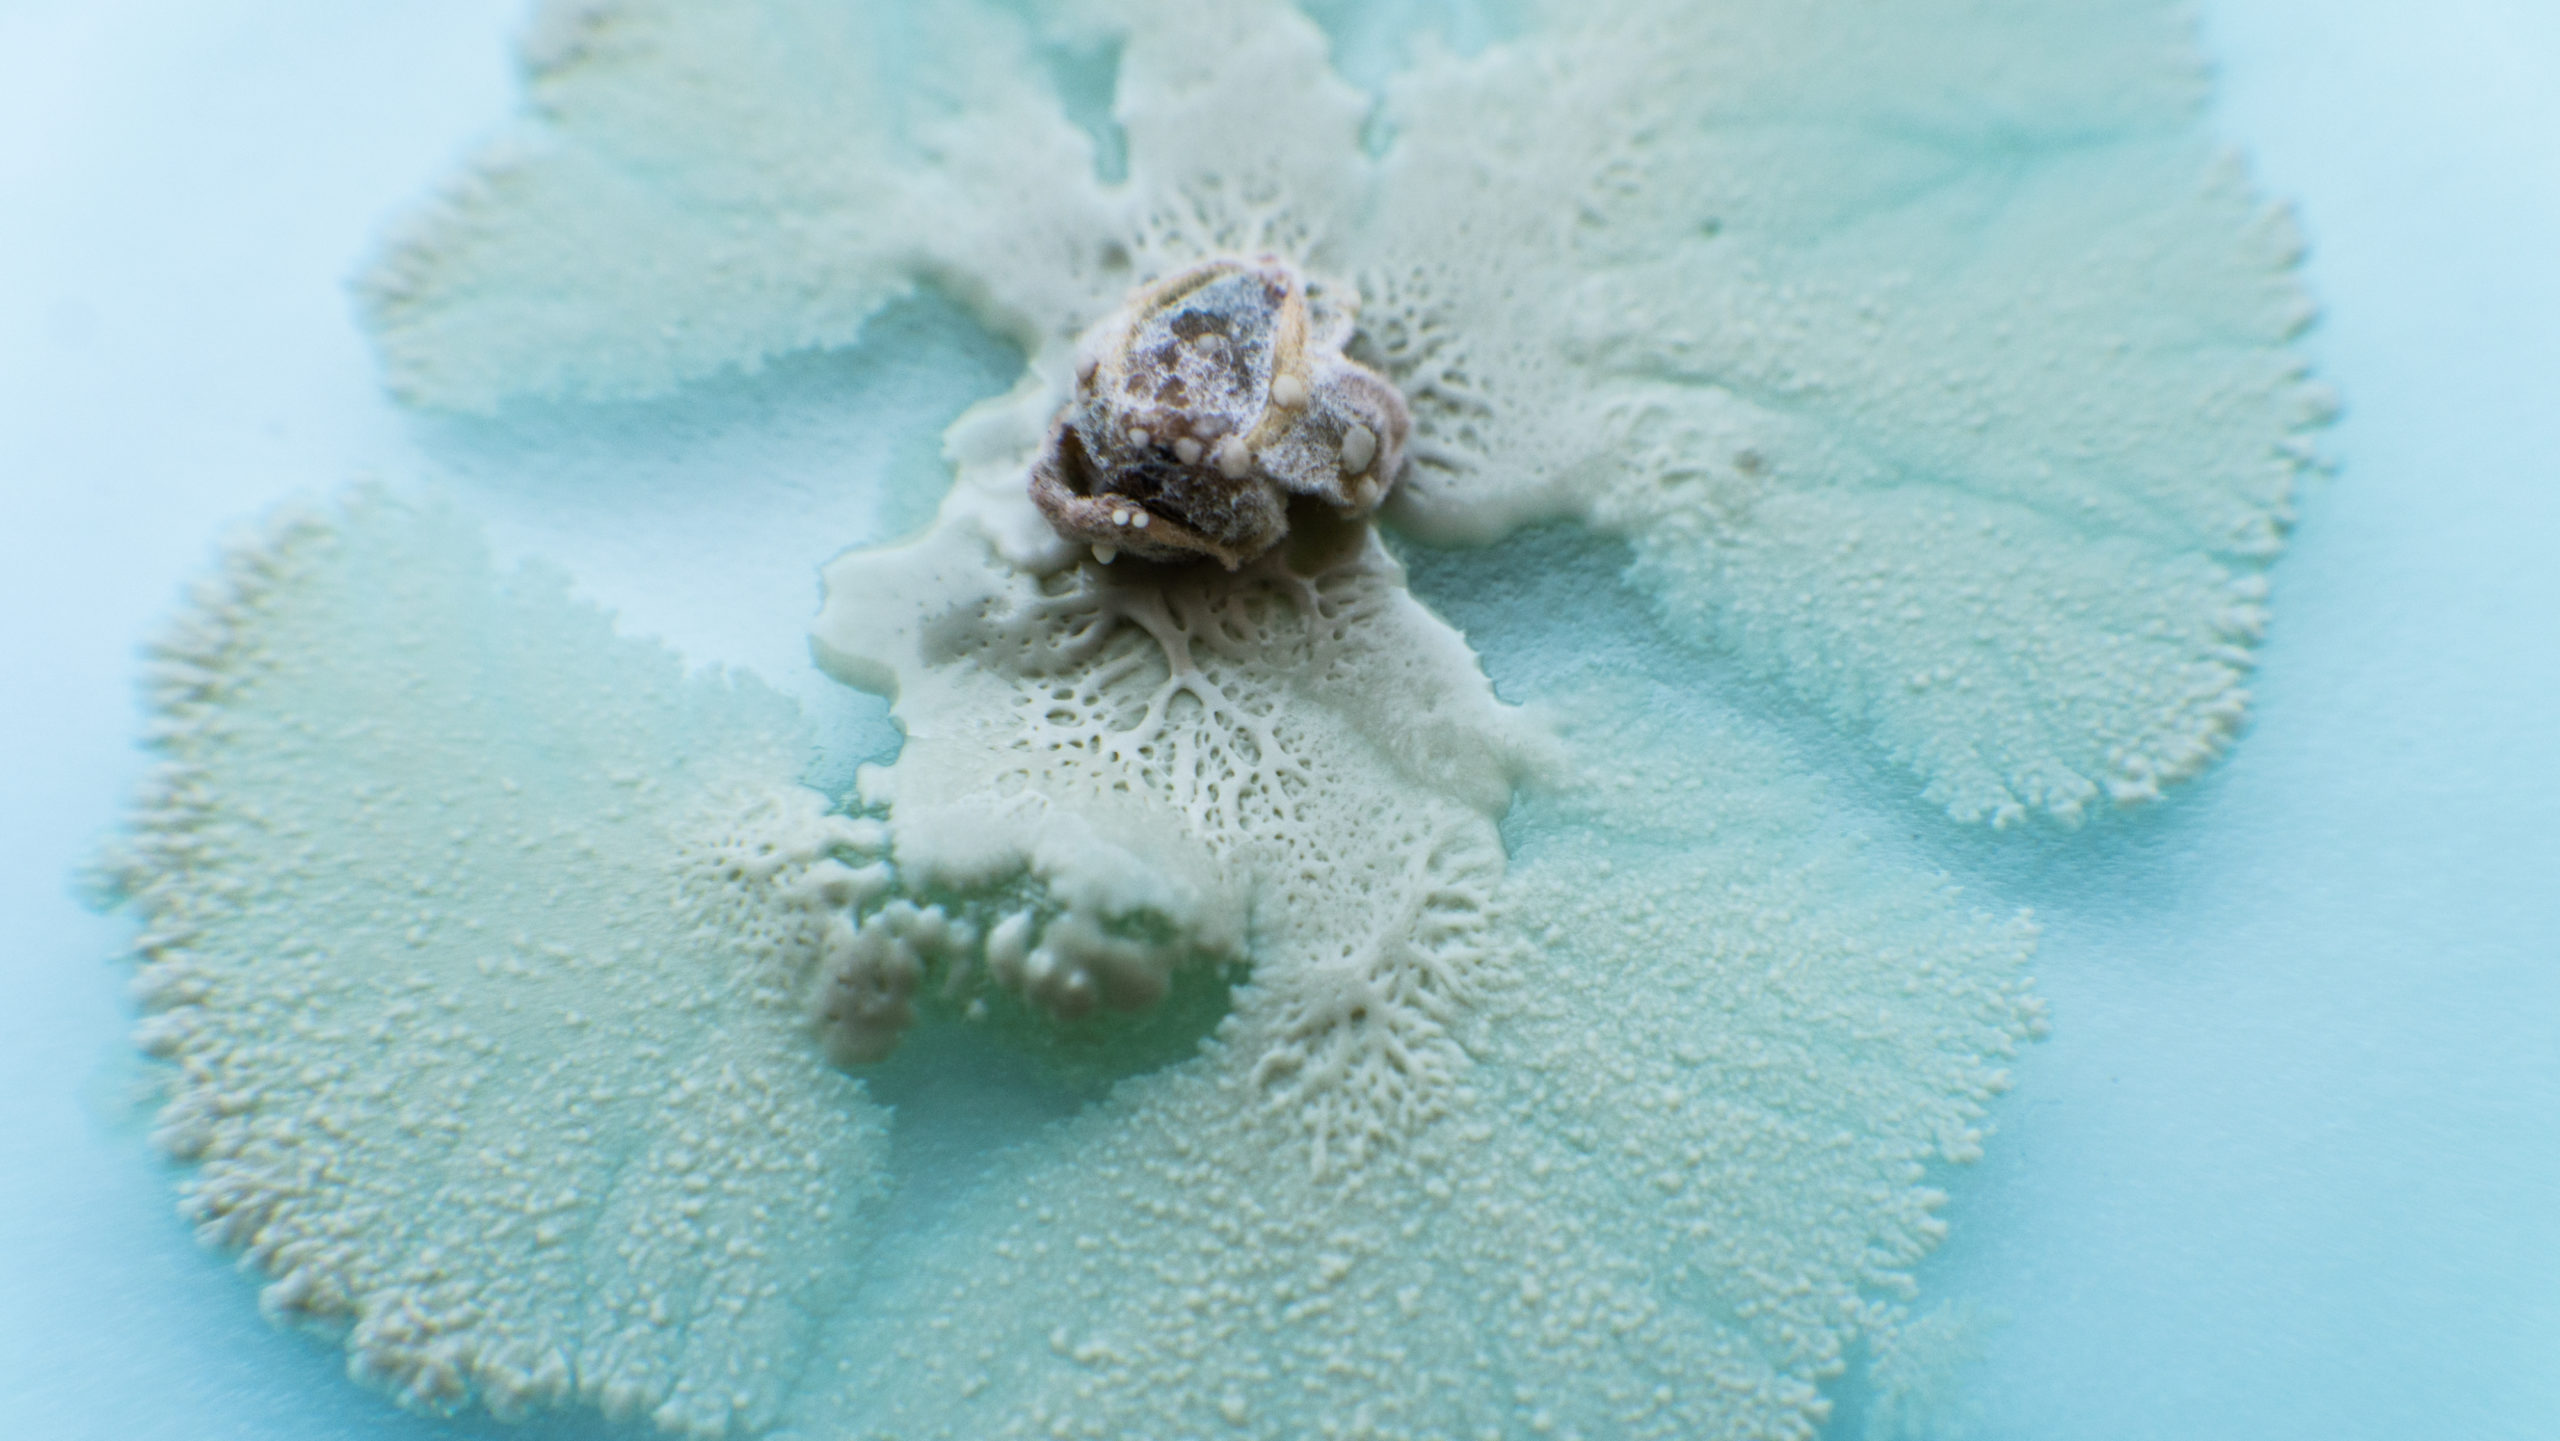
изготовление грибных материалов 2

Изготовление инновационных грибных материалов и регулирование их физических свойств
Ученые во всем мире заняты поисками способов внедрения живых биологических систем в материаловедение и нанотехнологии, с целью получения материалов из биологических ресурсов, полученных контролируемыми способами. Их усилия направлены на разработку новых материалов, которые не будут загрязнять природную среду.
Зачем нам новые материалы?
Главным стимулом исследований полимерных материалов из возобновляемых ресурсов являются глобальные проблемы деградации окружающей среды в результате широкого использования синтетических пластмасс и исчерпание ископаемых ресурсов. В этой области исследовательские усилия направлены на разработку из биомассы растительного, животного и бактериального происхождения таких полимерных материалов как целлюлоза, лигнин, пектин, белки и полиэфиры. Эти материалы, как правило, являются устойчивыми, биосовместимыми, биоразлагаемыми с широким спектром свойств. Однако, технологии их извлечения дорого стоят, требуют длительного времени и дают малый объем продукции на выходе. По этой причине такие материалы, хотя и могут решить различные экологические проблемы, все еще имеют высокую стоимость и ограниченное применение.
Какое решение предлагают ученые?
Источник: Adobe Stock/cendeced
Стратегией преодоления этих проблем может стать разработка композитных биоматериалов, свойства которых можно будет контролировать и настраивать в процессе их роста. Чтобы после его завершения материалы были готовы к использованию без необходимости применения дорогих и сложных методов обработки. Именно к такого рода материалам относится мицелий или вегетативная нижняя часть грибов.
Мицелий считается самым большим живым организмом на земле. Например, сеть мицелия осеннего опенка занимает почти 10 км2 в Голубых горах (Орегон, США). [1] Нити волокнистого мицелия называются гифами и состоят из удлиненных клеток. Эти клетки отделены друг от друга внутренними пористыми поперечными стенками (септами) и заключены вместе в трубчатую клеточную стенку. Клеточная стенка выполняет несколько физиологических функций в морфогенезе гриба, защищая гифы и обеспечивая механическую прочность всего мицелия. Она состоит из хитина, глюканов и внешнего слоя белков, таких как маннопротеины и гидрофобины.
Рост гиф происходит за счет расширения клеточной мембраны и клеточной стенки на кончике гифы. Мицелий состоит из хитина, целлюлозы, белков и других веществ, и представляет собой природный полимерный композитный волокнистый материал. Учитывая его уникальную структуру и состав, можно прогнозировать производство разнообразных материалов на основе мицелия.
Какие материалы уже производят?

Источник: facebook.com/ecovative
До настоящего времени производством пеноматериалов из биомассы на основе мицелия в основном занималась американская компания Ecovative [1]. Сейчас активные исследования ведутся в области производства на обширных площадях саморастущих волокнистых композитных материалов в промышленном масштабе . При этом особое внимание уделяется регулированию физических свойств мицелия путем изменения условий его выращивания.
Отличным примером таких исследований являются эксперименты по сравнительному культивированию двух видов съедобных и лекарственных грибов Ganoderma lucidum и Pleurotus ostreatus на двух субстратах в виде целлюлозы и целлюлозы/картофельного крахмала. В результате было установлено, что конечные волокнистые структуры характеризуются различными относительными концентрациями полисахаридов, липидов, белков и хитина, в зависимости от вида субстрата. Это объясняет их различия в морфологии и механических свойствах [2]. При этом была обнаружена корреляция величин соответствующих показателей механических свойств и концентрации картофельного крахмала (декстрозы) в субстрате.
Поиск и разработка инновационных экологичный материалов — важная работа для всех отраслей промышленности, без которой наше будущее на планете весьма туманно. Поэтому нам так интересно следить за открытиями ученых и ролью грибов в этом важном для всех нас процессе.
Статья подготовлена с использованием материалов Михаила Владимировича Вишневского.
Источники:
- Hawksworth D. L. The magnitude of fungal diversity: the 1.5 million species estimate revisited. Mycological Research, 2001, v. 105, pp. 1422–1432.
- Zeller P., Zocher D. Ecovative’s Breakthrough Biomaterials. Fungi Magazine, 2012, v. 5, pp. 51–56.
- Haneef M., Ceseracciu L., Canale C. et al. Advanced materials from fungal mycelium: fabrication and tuning of physical properties, Scientific Reports, 2017, v. 7, an 41292.
















